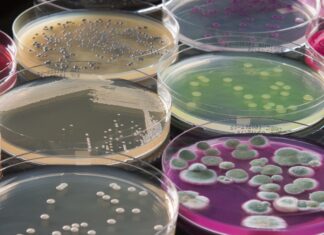
Инновационные методы в микробиологии

Разновидности роллов: самые популярные
Стоит учитывать тот факт, что в Японии очень мало людей, которые имеют лишний вес. Все дело в том, что у них очень эффективная система питания. Именно потому суши диета стала одной из самых популярных среди людей. Если вы хотите...
Почему пироги так популярны ?
Пироги можно назвать одним из наиболее популярных блюд. Такая тенденция сохраняется даже несмотря на то, что появилось немало альтернативы. В некоторых странах они являются национальным блюдом. Их изготовление сродни доброй традиции. Кроме того, пироги могу быть очень вкусными, поражая...
Как определиться с выбором профессии?
В современном мире выбор профессии играет ключевую роль в определении нашего будущего. Правильный выбор профессии обеспечивает нам удовлетворение от работы, карьерный рост и материальное благополучие. Однако многие сталкиваются с трудностями при определении своего пути, особенно если интересы и склонности...
Онлайн-казино Восток: Роль в развитии киберспорта в Казахстане
Онлайн-гемблинг и киберспорт — два стремительно развивающихся направления цифровых развлечений, которые всё чаще пересекаются. В Казахстане эта тенденция проявляется особенно заметно. Одним из ярких примеров такого взаимодействия стало участие онлайн-казино Восток в поддержке и популяризации киберспорта на национальном уровне....
Старые доллары в 2025 году: как обменять повреждённые купюры и не выйти в минус
Где обменять ветхие доллары — вопрос, который немедленно всплывает, когда в кошельке обнаруживается заломанная «сотка» девяностых или из ящика стола выпадает выцветшая «двадцатка». Российские кассы стали строже: привычное «принимаем всё» сменилось вежливым «извините». Ниже — пошаговое руководство, почему так...
Защита от кибератак: простые шаги для безопасности в цифровом мире
В современном мире, где почти все мы проводим большую часть времени в интернете, тема защиты от кибератак становится особенно важной. Киберпреступники придумывают все новые и новые способы проникнуть в наши устройства, украсть личные данные или даже заблокировать доступ к...
Инновационные методы в микробиологии
Микробиология – это наука о микроорганизмах, которые обладают огромным влиянием на жизнь на Земле. Открытие и изучение микроорганизмов стало ключом к пониманию многих биологических процессов и явлений. Сегодня развитие инновационных методов в микробиологии позволяет применять их в различных...
Современный выбор дверей для безопасного и комфортного пространства
При выборе дверей для дома, офиса, склада или общественного помещения важно учитывать не только внешний вид и цену, но и соответствие конструкции функциональному назначению. Сегодня в числе наиболее востребованных решений — пластиковые входные двери и противопожарные двери. Эти категории...
Почему все больше людей выбирают окна ПВХ: аргументы в пользу самого практичного решения
Современные окна все чаще ассоциируется именно с ПВХ-конструкциями. Благодаря сочетанию практичности, долговечности и доступной цены, пластиковые окна давно стали стандартом для городских квартир и частных домов. Они не хуже алюминиевых и деревянных аналогов, что связано с большим количеством своих...
Учет рабочего времени: как сделать его простым и эффективным
Сегодня сложно представить успешный бизнес без четкого контроля за временем, которое сотрудники проводят на работе. Учет рабочего времени — это одна из ключевых задач для любой компании. Но зачем он нужен и как сделать его не только обязательной формальностью,...